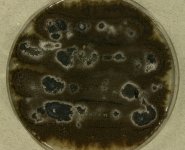

<< back to search
IMAGES:

Search Details
add to cart
| UAMH Number: | 9209 |
|---|---|
| Species Name: | Cephalotrichum purpureofuscum |
| Type: | |
| Synonyms: | Aspergillus purpureofuscus / Cephalotrichum brassicicola / Cephalotrichum brevipes / Cephalotrichum leucocephalum / Cephalotrichum medium / Doratomyces medius / Doratomyces purpureofuscus / Graphium griseum / Graphium leucocephalum / Graphium perpusillum / Graphium pusillum / Pachnocybe grisea / Periconia brassicaecola / Periconia brassicicola / Periconia discolor / Periconia fusca / Pycnostysanus medius / Sporocybe brassicaecola / Sporocybe brassicicola / Sporocybe brevipes / Sporocybe grisea / Sporocybe sacchari / Stilbum brevipes / Stysanopsis media / Stysanus brevipes / Stysanus fuscus / Stysanus mandlii / Stysanus medius |
| Taxonomy: | FUNGI Ascomycota, Sordariomycetes, Microascales, Microascaceae |
| Strain History: | S.P. Abbott (SA-M209) -> UAMH |
| Substrate: | indoor air of school library, Anderson sampler | Location: | CANADA British Columbia, Pemberton (GEO: 50.317,-122.8) |
| Isolator: | S.P. Abbott (SA-M209) |
| Isolation Date: | 1998-02-18 |
| Date Received: | 1998-03-09 |
| Characters: | SYSTEMATICS/ TAXONOMY Cephalotrichum and Doratomyces species - Abbott SP, Holomorph studies of the Microascaceae, Ph.D. dissertation, 2000 (Click for publications citing UAMH 9209) |
| Compounds: | |
| Cross Reference: | |
| Collections: | Living Strains; Dried Herbarium Material |
| Pathogenic Potential: | Human: no | Animal: no | Plant: no |
| Biosafety Risk Group: | RG1 (check the PHAC ePATHogen Risk Group Database for updates) |
| Regulatory Requirements: | No restrictions for Canadian requesters. International requesters must provide all legally required importation documentation prior to shipment. Plant pathogenicity status may be verified by using the USDA Agricultural Research Service (ARS) Fungal Database |
| MycoBank ID: | 294131 |
IMAGES: